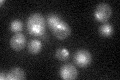
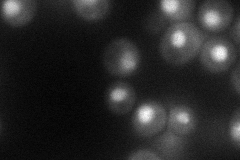
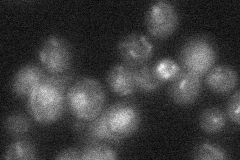
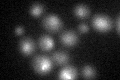

View description
Subunit of the condensin complex; required for establishment and maintenance of chromosome condensation, chromosome segregation and chromatin binding of the condensin complex; required for clustering of tRNA genes at the nucleolus
Localization:
Intensity:
Fold change:
Significance:
-
C’ GFP library in SD
nucleus23.54 -
N' NOP1pr-GFP in SD
nucleus58.0093 -
N' TEF2pr-mCherry in SD

nucleus28.6905 -
N' NATIVEpr-GFP in SD
ambiguous,punctate20.9402 -
N' TEF2pr-VC and Cyto-VN in SD

#N/A0 -
C’ GFP library in SD+DTT
nucleus22.510.95No -
C’ GFP library in SD+H2O2

nucleus27.351.16No -
C’ GFP library in Starvation Media

nucleus24.681.04No -
C’ GFP library on the background of Pup2-DaMP

N/A -
C’ GFP library on the background of CCT mutant

N/A0N/AYes
